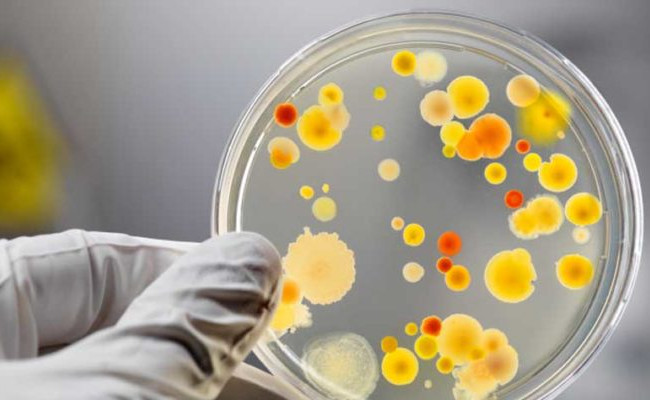
Один ребенок умер: беременная мать и дети отравились на Волыни

Один ребенок умер: беременная мать и дети отравились на Волыни
За 2 дня, в период с 17-18 сентября за медпомощью в Камень-Каширскую центральную районную больницу обратилось пять человек с проявлениями отравления. Среди пострадавших двое детей по 2 года года, двое детей по 4 года года и беременная женщина. Об этом сообщает пресс-служба Волынского обласного лабораторного центра.
"Заболевшие члены обеих семей из с. Боровно Камень-Каширского района и с. Рованцы Луцкого района. В связи с тяжестью состояния, двухлетний мальчик был госпитализирован в реанимационное отделение Камень-Каширской центральной районной больницы, где в 05:15 часов 18 сентября умер. Еще один ребенок из этой семьи переведен для дальнейшего лечения в Волынскую областную инфекционную больницу. Всем больным установлен предварительный диагноз «пищевая токсикоинфекция», однако, рассматриваются и другие версии заболевания, - сказано в сообщении.
С целью установления причин возникновения группового заболевания начато эпидемиологическое расследование в очаге в с. Боровно Камень-Каширского района, а также в лечебных учреждениях по месту госпитализации больных.
В домашнем очаге на исследования отобраны пробы пищевых продуктов, питьевой воды, смывы с объектов внешней среды. Проведено бактериологическое обследование контактных лиц. Материал в работе. За контактными лицами установлено медицинское наблюдение.
Проведение противоэпидемических мероприятий продолжается.
Напомним, ранее «Судебно-юридическая газета» сообщала о причинах отравлениях детей в Днепре. По результатам эпидемиологического исследования, которое проводили специалисты главного управления Госпродпотребслужбы в Днепропетровской области, главной причиной недуга школьников стала некачественная питьевая вода.







































